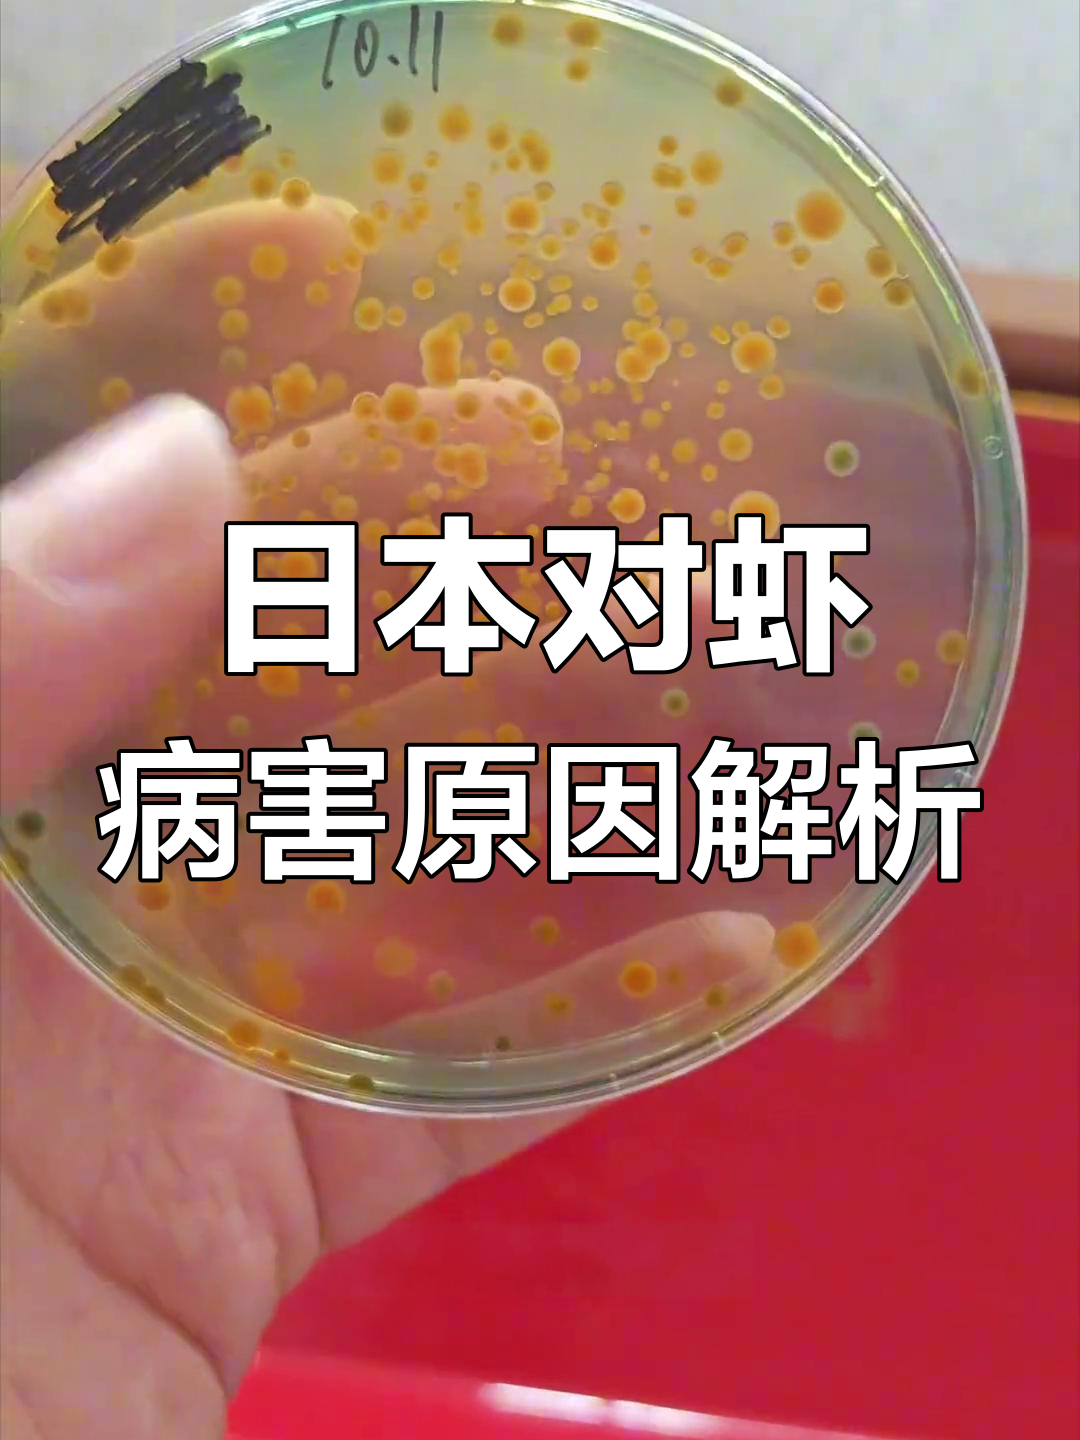
盲目消杀适得其反,日本对虾黑鳃烂鳃病因分析

日本对虾土塘养殖相关视频
日本对虾土塘养殖视频列表
-
 01:15
日本对虾养殖要点与防控措施 用户:周主厨餐饮笔记
01:15
日本对虾养殖要点与防控措施 用户:周主厨餐饮笔记 -
00:28
日本虾养殖岛流行技术有哪些? 用户:百度文库 -
01:25
日本对虾:美味与保健并重,养殖前景广阔 用户:鱼贝小张董 -
 00:27
日本对虾高位池养殖揭秘,底臭问题如何解决 用户:稳稳地约定
00:27
日本对虾高位池养殖揭秘,底臭问题如何解决 用户:稳稳地约定 -
 00:15
日本对虾高密度养殖:无沙清水循环水技术 用户:小橙宅探
00:15
日本对虾高密度养殖:无沙清水循环水技术 用户:小橙宅探 -
 02:29
九节虾养殖技巧:从饵料投喂到水质管理全攻略 用户:二次元传送门
02:29
九节虾养殖技巧:从饵料投喂到水质管理全攻略 用户:二次元传送门 -
 00:26
00:26
-
00:45
日本对虾养殖难题:纤毛虫病与药物使用 用户:不与愚者争 -
 00:11
车虾工厂化养殖全纪录,探秘基围虾、花虾和日本对虾的养殖过程 用户:草原逐风者
00:11
车虾工厂化养殖全纪录,探秘基围虾、花虾和日本对虾的养殖过程 用户:草原逐风者 -
01:24
盲目消杀适得其反,日本对虾黑鳃烂鳃病因分析 用户:路过打酱油的
01:24
盲目消杀适得其反,日本对虾黑鳃烂鳃病因分析 用户:路过打酱油的 -
 01:00
揭秘!日本对虾天价背后的秘密? 用户:雨萌的欢乐岛
01:00
揭秘!日本对虾天价背后的秘密? 用户:雨萌的欢乐岛 -
00:22
日本对虾,为何喜欢钻沙?今天就跟您分享! 用户:养虾 -
 00:38
虾价飙升,170元一斤!养殖户预测价格还将继续上涨 用户:佳期如梦一场
00:38
虾价飙升,170元一斤!养殖户预测价格还将继续上涨 用户:佳期如梦一场 -
 00:49
日本对虾价格飙升,未来是否会成新宠? 用户:给我一份麻薯
00:49
日本对虾价格飙升,未来是否会成新宠? 用户:给我一份麻薯 -
 00:53
日本对虾尾部蓝色,与斑节区别明显 用户:猫在我脚下
00:53
日本对虾尾部蓝色,与斑节区别明显 用户:猫在我脚下 -
 01:26
罗虾价格暴涨,日本对虾保持平稳 用户:陈式行道长
01:26
罗虾价格暴涨,日本对虾保持平稳 用户:陈式行道长 -
01:54
养虾ph值多少正常 用户:林业卫士 -
01:42
花虾是淡水还是海水养殖 用户:水果直达 -
 00:38
湛江对虾频现怪病,养殖户苦不堪言! 用户:老阅者书探社
00:38
湛江对虾频现怪病,养殖户苦不堪言! 用户:老阅者书探社 -
01:44
补充生物资源!近6000万尾日本对虾放流围头湾,改善水域生态 用户:福建帮帮团 -
01:58
日本对虾:海水对虾种类之一 用户:秒懂自然 -
 00:10
想转养花虾?这些因素你得考虑 用户:不留余地
00:10
想转养花虾?这些因素你得考虑 用户:不留余地 -
01:52
日本对虾和斑节对虾区别 用户:星河漫步 -
 01:42
养殖虾卫生堪忧,市场八成产品你敢放心食用吗? 用户:浮生如梦
01:42
养殖虾卫生堪忧,市场八成产品你敢放心食用吗? 用户:浮生如梦 -
 00:31
日本对虾状态良好,欢迎订购 用户:嘉嘉姐小课堂
00:31
日本对虾状态良好,欢迎订购 用户:嘉嘉姐小课堂 -
00:22
日本对虾苗与车虾标粗苗:2-3厘米规格详解 用户:花屿气球工坊 -
02:55
什么养殖最赚钱 用户:绿色守护 -
02:23
竹节虾与基围虾的区别 用户:百度网友0b04af7 -
 00:51
养殖池放沙的秘密:日本对虾为何爱扒? 用户:美妆指南
00:51
养殖池放沙的秘密:日本对虾为何爱扒? 用户:美妆指南 -
02:19
日本对虾无沙养殖技术 用户:绿色守护 -
01:50
日本对虾养殖最忌三种 用户:deerquest -
 00:14
探访车虾工厂化养殖基地,了解日本对虾的成长过程 用户:追风少年
00:14
探访车虾工厂化养殖基地,了解日本对虾的成长过程 用户:追风少年